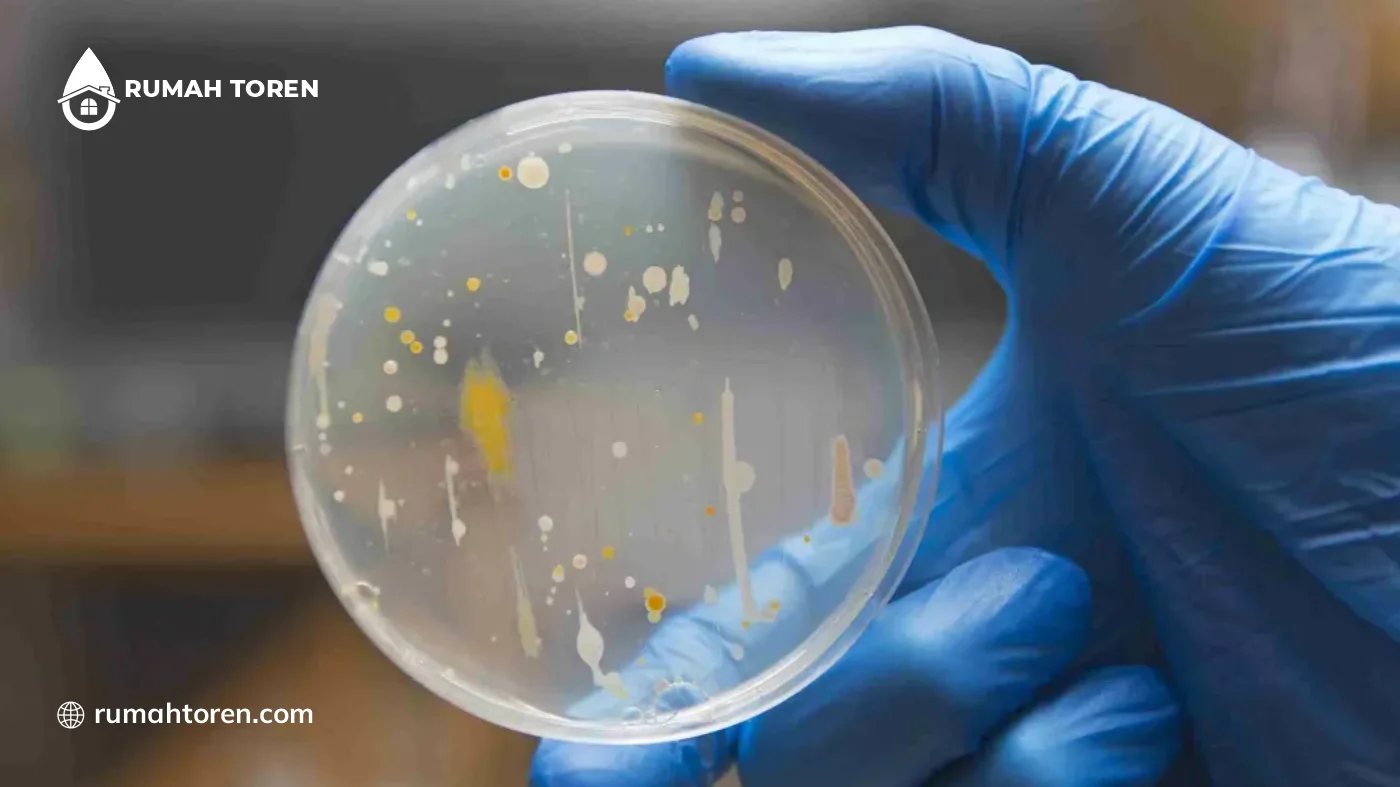
Cara Mudah Tes Kandungan Coliform di Air

Tes Kandungan Coliform Air – Menjamin keamanan air yang penggunaannya untuk kebutuhan sehari-hari merupakan langkah penting tersendiri.
Akan tetapi, banyak pemiliknya sering kali mengabaikan potensi bahaya kecil yang bersembunyi dalam tempat penampungan air mereka.
Sebenarnya, keberadaan bakteri Coliform dalam toren air menjadi indikator utama adanya kontaminasi kebersihan yang cukup serius.
Maka dari itu, bisa untuk mencoba tes kandungan Coliform pada air di toren untuk memberikan keamanan tersendiri.
Pemahaman yang baik tentang kebersihan air akan mencegah penyebaran penyakit saluran pencernaan berbahaya.
Sebagai informasi bahwa bakteri Coliform tidak bisa melihatnya secara langsung oleh mata telanjang manusia tanpa bantuan alat.
Melalui artikel kali ini akan menjelaskan cara tes kandungan bakteri tersebut pada air toren. Jadi, untuk lebih jelasnya simak saja artikel berikut.
Cara Mudah Tes Kandungan Coliform di Air
Melakukan deteksi dini terhadap keberadaan bakteri berbahaya kini tidak lagi harus selalu bergantung pada peralatan laboratorium mahal.
Akan tetapi perlu mengikuti prosedur pengambilan sampel yang teliti agar hasilnya memiliki tingkat akurasi tinggi.
Nah, berikut ini ada beberapa cara mudah tes kandungan bakteri Coliform pada air yaitu:
1. Penggunaan Wadah Sampel Steril
Langkah pertama paling penting adalah menggunakan botol sampel yang sudah bersih agar tidak ada kontaminasi luar.
Jangan menyentuh bagian dalam tutup botol dengan tangan kosong karena bakteri dari kulit bisa merusak hasil pengujiannya.
2. Teknik Pengambilan Sampel Air yang Benar
Nyalakan keran air dan biarkan mengalir selama 1 hingga 2 menit sebelum memasukkan airnya ke botol sampel. Langkah ini bertujuan untuk membuang air yang mengendap lama dalam pipanya.
3. Menggunakan Alat Uji Mandiri
Bisa membeli paket uji mandiri yang tersedia pada toko kesehatan untuk mendeteksi bakteri secara praktis.
Alat ini biasanya berisi tabung reaksi dengan media cair yang akan bereaksi jika terkena bakteri jahat.
4. Pengamatan Perubahan Warna Cairan
Perhatikan perubahan warna pada sampel air setelah tercampur dengan reagen khusus selama periode waktu tertentu, biasanya 24 jam.
Jika air berubah menjadi kuning pekat atau ungu, itu menunjukkan adanya aktivitas metabolisme bakteri.
5. Tes Pembentukan Gas dalam Tabung Reaksi
Amati apakah muncul gelembung gas kecil dalam tabung sampel yang telah tersimpan pada suhu ruang yang hangat.
6. Uji Sinar Ultraviolet
Gunakan lampu sinar UV dalam ruangan gelap untuk melihat apakah sampel air mengeluarkan cahaya berpendar biru.
7. Pemeriksaan Melalui Laboratorium Kesehatan
Bawalah sampel air yang sudah mengambilnya ke laboratorium kesehatan daerah untuk mendapatkan hasil pengujian secara profesional.
8. Deteksi Bau Busuk yang Tidak Wajar
Hiruplah aroma sampel air yang sudah mendiamkannya dalam wadah tertutup selama 1 hari penuh pada tempat gelap.
Bakteri yang berkembang biak biasanya akan mengeluarkan bau belerang atau aroma busuk yang menyengat hidung.
Tips Menghilangkan Kandungan Coliform Air pada Toren

Mengatasi masalah kontaminasi bakteri dalam sistem penampungan air memerlukan tindakan yang cepat dan sistematis.
Akan tetapi tidak boleh hanya sekadar menguras air tanpa melakukan proses disinfeksi yang menyeluruh pada seluruh dindingnya.
Berikut ini berbagai tips menghilangkan kandungan Coliform air pada toren yaitu:
1. Pengurasan Total dan Pembersihan Fisik
Langkah pertama adalah membuang seluruh isi air dalam toren dan menyikat habis semua lumut atau lendir yang menempel pada dinding bagian dalam.
2. Disinfeksi Menggunakan Larutan Klorin
Gunakanlah larutan klorin atau kaporit dengan dosis yang tepat untuk membunuh sisa-sisa kuman yang tidak terlihat oleh mata.
Campurkan kaporit ke dalam sedikit air, lalu usapkan atau semprotkan secara merata ke seluruh permukaan dinding dalam toren.
3. Pembersihan Jalur Pipa Distribusi
Jangan lupa untuk mengalirkan air berklorin dari toren ke seluruh keran agar pipa distribusi juga ikut steril.
Biarkan larutan berada dalam pipa selama beberapa jam sebelum membilasnya hingga bersih.
4. Pemasangan Lampu Ultraviolet (UV Sterilizer)
Pasanglah perangkat sinar ultraviolet pada jalur pipa keluar (outlet) toren untuk mematikan bakteri yang mungkin masih terbawa arus air.
Radiasi sinar UV akan merusak DNA kuman sehingga mereka tidak bisa berkembang biak.
5. Menutup Rapat Ventilasi dan Celah Toren
Pastikan penutup toren terkunci rapat dan pasanglah saringan halus pada lubang udara agar serangga tidak masuk.
6. Penggunaan Filter Air Sedimen 0.1 Mikron
Pasanglah filter air dengan kerapatan pori-pori yang kecil pada jalur masuk (inlet) sebelum air masuk ke dalam toren.
Filter ini berfungsi menyaring partikel organik dan bakteri yang ukurannya sangat kecil.
7. Melakukan Tes Laboratorium Pasca Pembersihan
Setelah semua proses selesai, lakukanlah kembali tes kandungan Coliform air untuk memastikan bahwa angka kuman sudah mencapai nol.
Rekomendasi Toren Air Slim Merk Grand

Setelah memahami bahaya bakteri maka pemilihan tempat penampungan air yang tepat menjadi solusi jangka panjang tersendiri.
Toren air Slim merk Grand bisa menjadi pilihan tersendiri, karena ukurannya ramping sehingga bisa masuk ke dalam ruangan.
Jadi, tidak perlu khawatir terpapar berbagai perubahan cuaca ekstrem di luar ruangan. Toren slim merk Grand sendiri menggunakan bahan baku HDPE murni tanpa bahan campuran apapun.
Sehingga memiliki ketahanan sangat bagus terhadap segala perubahan cuaca ekstrem dalam jangka panjang.
Toren slim merk Grand sendiri sudah anti lumut dan anti virus. Hal ini yang menjadikannya aman dalam menyimpan air untuk langsung konsumsi.
Saat ini sudah tersedia berbagai pilihan toren dengan kualitas terbaik dan menarik. Oleh karena itu, untuk informasi selengkapnya bisa langsung kunjungi marketplace rumah toren dan hubungi Whatsapp yang tertera berikut ini.






